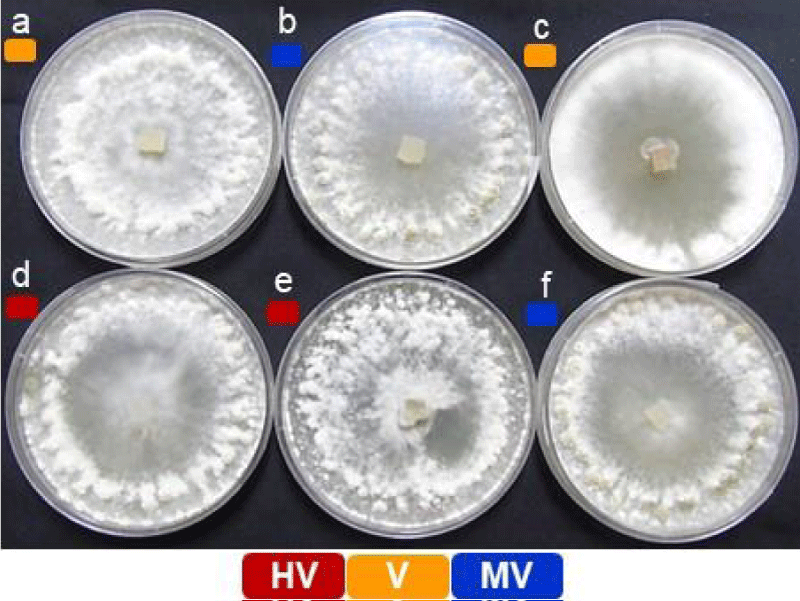

More Information
Submitted: December 21, 2022 | Approved: December 28, 2022 | Published: December 29, 2022
How to cite this article: Gupta NC, Arora S, Kundu A, Sharma P, Rao M, et al. UPLC-Q-TOF-MS-based untargeted studies of the secondary metabolites secreted by Sclerotinia sclerotiorum under the axenic condition. J Plant Sci Phytopathol. 2022; 6: 173-182.
DOI: 10.29328/journal.jpsp.1001095
Copyright License: © 2022 Gupta NC, et al. This is an open access article distributed under the Creative Commons Attribution License, which permits unrestricted use, distribution, and reproduction in any medium, provided the original work is properly cited.
Abbreviations: UPLC: Ultra Performance Liquid Chromatography; Q-TOF: Quadruple-Time of Flight; ESI: Electrospray Ionization; MS: Mass Spectrometry; CAZYmes: Carbohydrate Activating enzymes; CWDE: Cell Wall Degrading Enzymes; DHN: Di Hydroxy Naphthalene; HV: Highly Virulent; V: Virulent; MV: Moderately Virulent; ESR: Extramural Stem Rot; UPGMA: Unweighted Pair Group Method with Arithmetic mean; NTSYS: Numerical Taxonomy System; SM: Secondary Metabolites
UPLC-Q-TOF-MS-based untargeted studies of the secondary metabolites secreted by Sclerotinia sclerotiorum under the axenic condition
Navin Chandra Gupta1*#, Shaweta Arora1#, Aditi Kundu2, Pankaj Sharma3, Mahesh Rao1 and Ramcharan Bhattacharya1
1ICAR, National Institute for Plant Biotechnology, Pusa, New Delhi, India
2ICAR, Division of Agricultural Chemicals, IARI, Pusa, New Delhi, India
3ICAR, Directorate of Rapeseed and Mustard Research, Bharatpur, Rajasthan, India
#These authors contributed equally to this work
*Address for Correspondence: Dr. Navin Chandra Gupta, Senior Scientist, Brassica Lab, Room No. 14, LBS Building, ICAR, National Institute for Plant Biotechnology, Pusa, New Delhi, 110012, India, Email: [email protected]
The stem rot disease has emerged globally as a major threat to oilseed Brassica's productivity and seed quality. The generalist causal pathogen Sclerotinia sclerotiorum (Lib.) de Bary shows large variability in their aggressiveness and pathogenicity. Revealing the pathogen's metabolic profile and signaling components in host-pathogen interaction is fundamental in understanding host resistance to the disease. In this study, the metabolites released by the pathogenic strains of S. sclerotiorum under the axenic culture have been identified using the untargeted high-resolution UPLC-QTOF-ESI-MS/MS. The analysis of the ethyl acetate extracts of the S. sclerotiorum culture revealed ten major secondary metabolites namely, sclerin, sclerotinin-B, sclerone, melanin, bostrycoidin, botcinin-D, botcinin-A, gliovirin, scleramide, and botcinic acid. The later six metabolites are being reported for the first time in the culture extract of the S. sclerotiorum pathogen. Based on the overlapping and unique informative peaks in the chromatograms, the six S. sclerotiorum strains were grouped into three major clades in the phylogenetic analysis. The clustering based on metabolic profiles does not substantiate the diversity based on morphology or virulence differences over the host. The findings of the study signified the metabolites secreted under the axenic conditions are varies based on their growth and developmental stages and may not necessarily be the determining factors for their differential aggressiveness and virulence to their host.
The phytopathogen Sclerotinia sclerotiorum (Lib.) de Bary also known as white mold, causing stem rot disease in oilseed Brassica is a broad host range and ubiquitously distributed fungal pathogen [1]. The damage to crops by S. sclerotiorum leads to substantial yield losses in susceptible species. It is known to infect more than 400 plant species belonging to 278 genera of 75 families, including various economically important crops including rapeseed-mustard [2,3]. In Brassica, 10% - 80% yield reduction and deterioration of seed quality have been observed due to S. sclerotiorum infestation [4,5]. In Rajasthan, alone, which is a major Brassica-growing state in India, an estimated yield loss of 37%-92% has been reported due to this disease [6].
The life cycle of S. sclerotiorum has a very short biotrophic phase followed by a long necrotrophic phase that makes it hemibiotrophic in nature [7,8]. The life cycle of S. sclerotiorum involves mycelial growth, appressorium establishment, sclerotia formation, and apothecial and ascospore development followed by virulence [9,10]. Despite sporadic attempts have been made to study the key secondary metabolites produced by the pathogen and their role in virulence on host-pathogen interactions, the molecular mechanism of virulence for S. sclerotiorum is poorly understood and necessitates much research on the host and pathogen behaviors. Variation in pathogen virulence and host resistance determines the severity of the disease [7]. Virulence of the pathogen is mediated by various pathogenicity factors which include secretory proteins, effector candidates, secondary metabolites, and carbohydrate activating enzymes (CAZYmes) that include mostly the cell wall degrading enzymes (CWDEs) [11]. During the disease progression, host defense is usually suppressed by the fungal pathogen either by metabolizing the host secreters or promoting the transporter-based efflux system within the host [12,13]. The necrotrophic mode of infection involves suppression of host defense mediated by the pathogen secretory proteins and induction of cellular death in the host [14]. Oxalic acid, cell wall degrading enzymes like pectinase, cellulase, and xylanase have been found as the major disease-establishing factors which enable the S. sclerotiorum entry inside the host. Initiation of the infection is immediately followed by changing the cellular ion efflux of the host cells and degradation of the cell wall components at the site of infection [15-17].
The secondary metabolites secreted by the pathogen at different stages of their interaction with the host serve diverse functions that include facilitation of the infection, escape from the host defense, signaling for cascading the infection, and nutrient uptake for survival and proliferation of the pathogen inside the host. Among them, some of the secondary metabolites secreted by the necrotrophs are broad-spectrum in action whereas many of them are host-specific [18,19]. The botrydial and botcinic acid secreted by Botrytis cinerea during pathogenesis have been found to induce tissue necrosis in the host [20,21]. The knock-out of transcriptional regulator BcReg1 in In-silico makes the pathogen ineffective to form lesions which was due to the lack of virulence factors botrydial and botcinic acid in the knock-outs [22]. In-silico analysis revealed various homologous clusters of In-silico in S. sclerotiorum to produce secondary metabolites such as carotenoids, dihydroxy napthalene (DHN) melanin, siderophores, and botcinic acid. Putative clusters of polyketides sclerin were also identified in S. sclerotiorum along with the ABC transporter which aided the suppression of the host defense response through efflux [23]. DHN melanin biosynthesis, reported in S. sclerotiorum [24] has been found to play an important role in increasing the longevity of the sclerotia [25]. Another metabolite scleramide was isolated from the sclerotial extracts of Aspergillus sclerotiorum [26] whereas sclerin was isolated from S. sclerotiorum. Both metabolites were found to play an important role in regulating the maturation and pigmentation of sclerotia [27]. Oxalic acid has been considered essential for the initiation of infection in the host as the oxalic acid-deficient strain of S. sclerotiorum showed reduced virulence in several host species [28].
The successful disease establishment seems to be an outcome of the cumulative effects of several downstream processes occurring within the host as well as in the pathogen following the interaction. Although a vast array of information related to different aspects of S. sclerotiorum infection has emanated from the recent transcriptomic, proteomic, and secretome studies, however, the wide diversity in S. sclerotiorum population remained a major hurdle. This also reflects a likely variation in the mechanism of their pathogenesis which permits further study. In oilseed Brassica, the molecular and metabolic processes that regulate the host resistance to S. sclerotiorum are largely unknown. Identifying the key metabolites which determine the aggressiveness of the pathogen is important to postulate novel targets for engineered host resistance. To date, a limited number of metabolites viz. DHN melanin, sclerin, sclerone, isosclerone, sclerolide, and sclerotinin A and B have been isolated and characterized in S. sclerotiorum [24,29]. Earlier, we categorized diverse isolates of the S. sclerotiorum into different pathogenicity groups [30]. Here, we have carried out comprehensive metabolite profiling of the six isolates of S. sclerotiorum, belonging to three different pathogenicity groups. The metabolites with their diversity under the axenic condition would add to the existing knowledge of the secondary metabolites secreted by S. sclerotiorum and their functions in pathogenesis.
Sclerotinia sclerotiorum isolates and its culture
From the pathogenically distinct 65 S. sclerotiorum isolates [30], two each from the highly virulent (HV; ESR-18, ESR-25), virulent (V; ESR-01, ESR-05), and moderately virulent isolates (MV; ESR-04, ESR-42), were randomly selected for metabolite profiling. For growing the inoculum, all the six isolates were inoculated on potato dextrose agar (PDA) medium and incubated at 22 ℃ ± 2 ℃ for 5 days. Mycelial mat from the 5 days old actively growing mycelial culture was scrapped and re-inoculated in 500 mL of potato dextrose broth (PDB) in 1L flask and grown in the dark at 22° ± 2 ℃for 10-days with continuous shaking at 120 rpm. The 10-day-old broth culture was filtered with a double layer of muslin cloth in a sterile 500 mL flask for further processing.
Extraction of fungal culture filtrate
The cell-free culture filtrates (250 mL) were extracted thrice with ethyl acetate (100 mL × 3). For distinct and clear solvent layer separation, 10 mL saturated sodium hydrochloride solution was added to each extract and shaken vigorously. The upper ethyl acetate layer was filtered out and passed through anhydrous sodium sulfate (20 g) to remove any traces of water. Liquid-liquid partitioning was followed to extract maximum secondary metabolites as described by Kundu, et al. [31]. Extracted ethyl acetate from the culture filtrates was evaporated under reduced pressure below 40 °C in a rotary evaporator (Heidolph, Germany) for obtaining the different amounts of the semisolid residues viz. 56 mg (ESR-01), 32 mg (ESR-04), 42 mg (ESR-05), 13 mg (ESR-25) and 67 mg (ESR-42). These extracts were subjected to six UPLC-QTOF-ESI-MS analyses for the separation and identification of the major secondary metabolites.
UPLC-QTOF-ESI-MS/MS analysis
UPLC-QTOF-ESI-MS/MS analysis was performed on an Acquity Ultra Performance Liquid Chromatography (UPLC) directly attached to a Quadrupole-Time of Flight mass spectrometer (Waters Corporation, Manchester, UK). The data acquisition was done with the MSE function in continuum mode in the range of m/z 50-1200. The MSE mode provides the full scan of MS data (low energy, 4V) and MS/MS data (high energy, 15-60V ramping), simultaneously. The ion source parameters were set as default which was fixed with the capillary 4.5kV, sampling cone 25V, extraction cone 5V, source temperature 250 °C, desolvation temperature 400 °C, desolvation gas flow 1000 L/h, and cone gas flow 30 L/h. The chromatographic separation was performed on an ACQUITY UPLC BEH C18 column (2.5 × 100 mm, 1.5 µm) at 30 °C. The mobile phase consisted of phase ‘A’ methanol: water (5:95) and phase ‘B’ methanol: water (95:5) with 0.1% formic acid in both phases. A gradient program was used with 0.5 mL min-1 flow rate, with 0-5 min 100% A, 5-10 min 60% A, 10-15 min 40% A, 15-18 min 60% A, 18-25 min 100% A. The injection volume was 3 µL and the samples were maintained at 25 °C throughout the analysis.
Molecular ion peak analysis and metabolite prediction
The molecular ion and fragment ion peaks of mass analysis were processed using the UNIFI software package version 1.7. Version (Waters Corporation, Manchester, UK). The database for the secondary metabolites was prepared in the UNIFI software [DG SANTE guideline]. An in-house database for the known species-specific fungal compounds with molecular masses and their elemental composition known in the public domain was constructed. Wherever the species-specific compounds were not available the genus-specific fungal metabolites were included. All the metabolites were identified based on their exact molecular and adduct ion peaks within the acceptable error mass (δ) value of 3 ppm. Tentative compounds were manually further inspected by comparing their mass fragmentation pattern. Chem Draw Ultra, version 15.0 (Bedford, MA, USA) was used for drawing the 2D structure of the compounds and their fragmentation patterns.
Phylogenetic analysis
Cluster analysis of UPLC-QTOF-MS peaks data was carried out using NTSYS (Numerical Taxonomy and multivariate analysis SYStem). The phenetic classification of NTSYS is based on similarity among the multivariate data generated from the patterns of biological diversity. An input file with scoring into 0, 1 binary matrix for the presence and absence of each peak was prepared. The UPGMA of the SHAN module of NTSYS-pc version 2.2 packages was applied to determine the similarity among the isolates using Jaccard's coefficient between each pair and the isolates were clustered together in the dendrogram.
S. sclerotiorum isolates and their pathogenicity variance
The pathogenicity grouping of S. sclerotiorum isolates includes ESR-01, ESR-04, ESR-05, ESR-18, ESR-25, and ESR-42 (Figure 1) [30]. The virulence grading was done for the individual isolates in terms of mean lesion length which is the function of individual isolates i.e., how fast the pathogen proliferates and establishes infection to develop lesion at the inoculation sites on the host. The virulence evaluation of the selected isolates has grouped them into highly virulent (HV; ESR-18 & ESR-25), virulent (V; ESR-05 & ESR-01), and moderately virulent (MV; ESR-04 & ESR-42) (Table 1). The longest stem lesion was observed in B. rapa var yellow sarson (NRCYS 5-2) with ESR-18 isolate whereas the smallest was observed in B. juncea (NRCDR-2) with ESR 42. The variability in the severity of infection with different isolates indicates the influence of both the virulence properties of the isolates as well as the defense characteristics of the host.
Figure 1: Morphological variability and pathogenic diversity among the six different isolates of Sclerotinia sclerotiorum. (a) ESR-01, (b) ESR-04, (c) ESR-05, (d) ESR-18, (e) ESR-25, and (f) ESR-42. Colored blocks depicting their pathogenicity grouping.
| Table 1: The S. sclerotiorum isolates with their geographical distribution and virulence grading assessed on Brassica cultivars based on the disease severity, measured in lesion length (cm). | |||||||
| Isolates | Source host | Provinces | Geographical locations | Mycelium growth on PDA (mm) at 72 h | Sclerotia/ plate | Mean Lesion length (cm) over the four Brassica cultivars | Virulence |
| ESR-01 | B. juncea | Rajasthan | 27º15’N; 77º30’ E | 85 | 40 | 17.7 | Virulent |
| ESR-04 | -do- | UP | 26°28'N; 80°24' E | 34 | 49 | 7.7 | Moderately Virulent |
| ESR-05 | B. rapa | UP | 25°28'N; 81°54' E | 90 | 33 | 14.5 | Virulent |
| ESR-18 | -do- | Punjab | 30°11'N; 75°00' E | 80 | 38 | 25.8 | Highly Virulent |
| ESR-25 | -do- | UP | 27°28'N; 77°41' E | 90 | 39 | 24.8 | Highly Virulent |
| ESR-42 | -do- | Rajasthan | 27º34’N; 77º37’ E | 77 | 38 | 8.8 | Moderately Virulent |
UPLC-QTOF-ESI-MS peak simulation and tentative metabolite profiling
UPLC-QTOF-ESI-MS analysis of ethyl acetate extracts of the six different S. sclerotiorum isolates revealed various characteristic peaks (S1-S6) corresponding to their molecular and adduct ions (S7). With the manual simulation of the UPLC-MS peaks, ten different metabolites namely, (i) sclerin, (ii) sclerotinin B, (iii) sclerone, (iv) bostrycoidin, (v) botcinin D, (vi) botcinin A, (vii) gliovirin, (viii) melanin, (ix) scleramide, and (x) botcinic acid were putatively identified (Figure 2). The metabolites along with their neutral, observed molecular mass and adducts are listed in Table 2. Reported sources of all the metabolites are also mentioned in Table 2 wherein, sclerin, sclerone, melanin, and sclerotinin B have already been reported in S. sclerotiorum whereas the six other metabolites from different fungal species. Botcinic acid, botcinin A, and botcinin D are reported in In-silico whereas bostrycoidin, gliovirin, and scleramide in Fusarium bostrycoides, Gliocladium virens, and Aspergillus sclerotiorum, respectively. Further, the comparative analysis of the identified secondary metabolites in six different isolates was delineated as shown in Table 3.
Figure 2: Tentative identification of the secondary metabolites in six different isolates of S. sclerotiorum using UPLC-Q-TOF-ESI-MS.
| Table 2: List of putative secondary metabolites identified with their retention time, neutral mass, observed molecular mass and adducts along with the source from which they were first reported | |||||
| Tentative metabolites | Molecular formula | Rt (min) | Neutral Mass (Da) | Observed m/z | Adduct |
| Sclerone | C10H10O3 | 3.02 | 178.0630 | 179.0706, 197.1319 | [H]+, [H+NH4]+ |
| Sclerin | C13H14O4 | 5.29 | 234.0892 | 235.1713 | [H]+ |
| Botcinic acid | C20H34O8 | 5.88 | 402.2254 | 403.1438 | [H]+ |
| Melanin | C18H10ON2O4 | 7.34 | 318.0640 | 319.3947, 336.1815 | [H]+, [NH4]+ |
| Botcinin D | C20H30O6 | 7.69 | 366.2042 | 367.1489 | [H]+ |
| Gliovirin | C20H20N2O8S2 | 8.84 | 480.5110 | 481.6326, 503.3604 | [H]+, [Na]+ |
| Botcinin A | C22H34O8 | 9.15 | 426.2254 | 426.2267 | [M]+ |
| Sclerotinin B | C12H14O5 | 9.05 | 238.0841 | 238.2365, 256.2719 | [M]+, [NH4]+ |
| Bostrycoidin | C15H11NO5 | 9.64 | 285.0637 | 285.3492 | [M]+ |
| Scleramide | C38H45N7O7 | 11.81 | 712.3380 | 713.5579 | [H]+ |
| Table 3: Comparative metabolite profiling based on differential analysis of fungal metabolites in six different isolates of S. sclerotiorum using UPLC-QTOF-MS. | |||||||
| S No. | Metabolites | ESR1 | ESR4 | ESR5 | ESR18 | ESR-25 | ESR42 |
| 1 | Sclerone | 197.1319 | 197.1319 | 197.1319 | 197.1319 | - | 197.1319 |
| 2 | Sclerin | - | 235.1713 | - | 235.1713 | 235.1713 | 235.1713 |
| 3 | Sclerotinin B | 256.2719 | 256.2719 | - | 256.2719 | - | 256.2719 |
| 4 | Bostrycoidin | 285.3492 | - | - | - | - | - |
| 5 | Melanin | 336.1815 | - | 336.1815 | - | - | 336.1815 |
| 6 | Botcinin D | - | 367.1489 | 367.1489 | 367.1489 | - | 367.1489 |
| 7 | Botcinic acid | - | 403.1438 | - | 403.1438 | - | 403.1438 |
| 8 | Botcinin A | - | 426.2267 | 426.2267 | - | 426.2267 | 426.2267 |
| 9 | Gliovirin | - | 503.3604 | 503.3604 | 503.3604 | - | 503.3604 |
| 10 | Scleramide | - | - | 713.5579 | 713.5579 | - | 713.5579 |
The total ion chromatogram (TIC) of the ethyl acetate extract of ESR-1 showed various characteristic peaks, leading to the identification of four major secondary metabolites namely, sclerone, sclerotinin B, bostrycoidin, and melanin (Figure 2). The first tentatively identified compound of ESR-01 was sclerone, eluted from the column at Rt 2.86 min interval, and exhibited distinct protonated molecular ion peak at m/z 179.0706 and ammoniated adduct ion peak at m/z 197.1319. Further, the fragmentation pattern in MS/MS analysis showed daughter ion peaks at m/z 169, formed due to the removal of carbonyl moiety (-CO, 28 amu) (Figure 3i). Similarly, sclerotinin B showed the characteristic molecular ion peak [M]+ at m/z 238.2365 and ammoniated adduct ion peak at m/z 256.2719. Furthermore, fragmentation of sclerotinin B resulted in daughter ion peaks at m/z 149, which originated due to the sequential removal of methyl (-CH3, 15 amu), carbonyl (-CO, 28 amu), and hydroxyl (-OH, -17 amu) moieties (Figure 3ii). On the other hand, bostrycoidin was characterized by its [M]+ peak at m/z 285.3492, further, fragmentation resulted in fragment ion peaks at m/z 239 after losing both the methyl (-CH3, 15 amu) and methoxy (-OCH3, 31 amu) moieties (Figure 3iii). The fourth metabolite of ESR-01 was identified as melanin which showed Rt 7.34 min with the characteristic protonated adduct ion peak at m/z 319.3947 and ammoniated adduct ion peak at m/z 336.1815 (Figure 3iv).
Figure 3: Mass fragmentation pattern of secondary metabolites. i) Sclerone, ii) Sclerotinin B, iii) Bostrycoidin and iv) Melanin of S. sclerotiorum using UPLC-Q-TOF-ESI-MS.
Similarly, the total ion chromatogram (TIC) of ESR-4 led to the identification of seven secondary metabolites sclerone, sclerin, sclerotinin B, botcinin A, D, botcinic acid, and scleramide (Figure 2). Sclerin was identified from its accurate protonated adduct ion peak at m/z 235.1713, which on the exposure of energy fragmented to form daughter ion peaks at m/z 178 and m/z 149 after subsequent elimination of two carbonyl and methyl groups, respectively (Figure 4i). Another two congeners of botcinin such as botcinin A and D were characterized by their accurate molecular ion peak at m/z 426.2267 and protonated adduct ion peak at m/z 367.1489, respectively. Further botcinin A possessed protonated adduct ion peak at m/z 426.2267, which was cleaved to remove the acetyl group followed by an alkyl ester side chain to get a daughter ion peak at m/z 383 and 243, respectively (Figure 4ii). Similarly, botcinin D showed protonated adduct ion peak at m/z 367.1489, which on fragmentation gave a major fragment ion peak at m/z 227 after the removal of side-chain alkyl ester (Figure 4iii). Similarly, scleramide exhibited protonated adduct ion peak at m/z 713.5579, which on fragmentation produced a daughter ion at m/z 149 (Figure 4iv).
Figure 4: Mass fragmentation pattern of secondary metabolites. i) Sclerin, ii) Botcinin A, iii) Botcinic acid and iv) Scleramide of S. sclerotiorum using UPLC-Q-TOF-ESI-MS/MS.
The TIC of ESR-5 showed six similar secondary metabolites such as sclerone, melanin, gliovirin, scleramide, botcinin A, and D (Figure 2). Except for gliovirin, the other five metabolites resembled the previously identified compounds. Thus, gliovirin was characterized by its protonated adduct ion peak at m/z 481.6326 along with the sodiated adduct ion peak at m/z 503.3604 (Figure 5i). Another secondary metabolite, botcinic acid exhibited protonated adduct ion peak at m/z 403.1438. Further fragmentation of parent ion on higher energy produced major daughter ion at m/z 344 after losing acidic moiety (Figure 5ii).
Figure 5: Mass fragmentation pattern of secondary metabolites. i) Gliovirin and ii) Botcinin D of S. sclerotiorum using UPLC-Q-TOF-ESI-MS/MS.
While the TIC of ESR-18 possessed characteristic [M]+ peaks, corresponding to seven secondary metabolites such as sclerone, sclerin, sclerotinin B, botcinin D, botcinic acid, gliovirin, and scleramide (Figure 2). However, the mass spectra of ethyl acetate fraction of ESR-25, unfortunately, showed very few peaks which are matching only with sclerin and botcinin A (Figure 2). Mass spectral analysis of ESR-42 comprised of various peaks corresponding to seven secondary metabolites such as sclerone, sclerin, sclerotinin B, melanin, botcinic acid, botcinin A, and scleramide.
Comparative metabolite profiling
The differential analysis of secondary metabolites in pathogenically diverse isolates of S. sclerotiorum (Table 3) revealed the release of the secondary metabolites under axenic conditions is independent of their virulence and that varies based on the isolate’s divergence. The observation has further been supported by the metabolite-based phylogeny that revealed the secondary metabolites secreted under the natural growth condition are not truly depicting the virulence of the pathogen and hence the virulence-based grouping of isolates do not corroborate the metabolite-based grouping (Figure 6). In UPLC-MS, ESR-42 has a maximum number of identified peaks including tentatively identified compounds such as sclerin, sclerotinin B, sclerone, botcinin D, and botcinin A, gliovirin, melanin, scleramide, botcinic acid except for bostrycoidin (Table 3). ESR-04 and ESR-18 have similar compounds identified except for botcinin A and scleramide which include sclerin, sclerotinin B, botcinin D, botcinin A, gliovirin, and botcinic acid. ESR-04 and ESR-18 differ from ESR-42 in the absence of botcinic acid, scleramide, and melanin. ESR-01 includes sclerotinin B, sclerone, bostrycoidin, and melanin whereas ESR-05 includes melanin, sclerone, botcinin D, scleramide, gliovirin, and botcinin A (Table 3). In the isolate ESR-25, only sclerin and botcinin A was detected. Among the ten prominent secretory metabolites identified in the axenic cultures of S. sclerotiorum isolates, six metabolites gliovirin, scleramide, botcinic acid, bostrycoidin, botcinin A & D were revealed for the first time in the present studies along with the four other metabolites sclerin, sclerone, sclerotinin-B, and melanin were known earlier (Figure 6).
Figure 6: Schematic representation of the secondary metabolites identified by LCMS analysis of the liquid culture of S. sclerotiorum pathogen. The left panel enlists the six additional putative SM and the right panel shows the known SM identified under the axenic condition.
Metabolite-based phylogeny of the S. sclerotiorum isolates
Phenetic studies were carried out based on identified ten major UPLC-QTOF-MS peaks scored as 1 and 0 for presence and absence, respectively in all the six isolates of the S. sclerotiorum. The data was analyzed by similarity-based UPGMA cluster analysis method using NTSYS software. The six isolates of the S. sclerotiorum belonging to three different Indian provinces Rajasthan, U.P., and Punjab were grouped into three major clades based on the number of informative characteristic peaks. Clade I carries the ESR-01 (V) and ESR-25 (HV) isolates and shared 45% similarity with the remaining isolates; whereas the three isolates ESR-04, -18, and -42 were present in clade II and solitary ESR-05 isolate was present in clade III with 58% similarity (Figure 7). Clade II with three isolates has further divided into two subgroups with 73% similarity in which subgroup I carry the ESR-04 (MV) and ESR-18 (HV) isolates whereas ESR-42, an MV isolates remained solitary in subgroup II (Figure 7).
Figure 7: Cluster dendrogram of the S. sclerotiorum isolates based on comparative metabolite profiling obtained in UPLC-QTOF-ESI-MS/MS analysis.
Sclerotinia stem rot disease causes yield losses in many crops throughout the world [2]. The use of chemical fungicides as the most prevalent control measure has never been effective due to uncertainty in doses and time of application in the field in addition to the incurred high cost [32,33]. Though the natural variation in host resistance has been identified in a few instances, the convergence of resistance to the cultivated varieties has not been achieved much. In addition to breeding efforts, parallel basic studies on the pathogen virulence and determinant of differential pathogenicity in S. sclerotiorum isolates are pivotal for the durability of resistance [34]. In the present study aggressiveness of the isolates belonging to pathogenically three different classes namely highly virulent (HV), virulent (V) and moderately virulent (MV) were compared based on their secreted secondary metabolites in growth culture. The assessment clustered ESR-01, a virulent isolate from Rajasthan, and ESR-25, a highly virulent isolate from UP together in the major clade I. ESR-04, an MV isolates from UP clustered together with HV isolate ESR-18, collected from Punjab, in subgroup I of the major clade II. The subgroup II of the major clad II consisted of a single MV isolate ESR-42 of Rajasthan which shared 73% similarity with the other two isolates present in subgroup I. Clade III represented the isolate ESR-05 from UP though it shared 58% similarity with the other isolates based on secreted metabolites. This signified the role of the metabolites in determining the virulence and pathogenicity of the isolates over the susceptible hosts. No influence of geographical location, as well as the source of origin of the isolates on their aggressiveness, has also been evident from earlier studies [30,35].
The disease severity of S. sclerotiorum involves a consequence of complex interactions between several factors including aggressiveness of the isolates and host resistance mechanisms [36]. The differential response of the cultivars to S. sclerotiorum isolates can be attributed to variable lignification of stem cortical cells and the number of cell layers in the cortex [36]. A study of different S. sclerotiorum isolates revealed that the hyphae in infection cushions of the highly virulent isolates were arranged together in dense parallel bundles whereas hyphae in infection cushions of a less virulent isolate were more diffused independently of the host genotype [36-38]. Moderately virulent isolates ESR-04 and -42 demonstrated a slow growth rate as compared to the other isolates whereas ESR-05 (V) has a high growth rate when the diameter of the lesions is at 72 hours post inoculation (hpi) was compared (Table 1). The growth rate of the pathogen was found to be positively related to the virulence of the isolates. The differential virulence of the isolates was also attributed to effector proteins, secondary metabolites, and carbohydrate activating enzymes [14,15]. Among the major pathogenicity factors such as proteinaceous effectors, secondary metabolites, and cell wall degrading enzymes , secondary metabolites are the less investigated aspect in infection by S. sclerotiorum [39]. Many necrotrophs are known to secrete broad-spectrum phytotoxic secondary metabolites to induce host tissue necrosis [40,41].
Many fungal secondary metabolite biosynthetic gene clusters remain silent under axenic conditions [42,43]. The transcriptional regulation of such genes is usually controlled by several external stimuli including environmental and host interacting factors [44]. The present study has also emphasized that the secreted secondary metabolites under axenic conditions may not be solely determining the virulence of the pathogen but it depends on the outcome of their firm interaction with the hosts. Hence, the role of secondary metabolites in standard cultivation condition and their relevance in fungal biology could not be neglected.
The UPLC-QTOF-ESI-MS/MS has been exploited extensively for non-target analysis of a wide range of secondary metabolites [45,46]. The S. sclerotiorum isolates under study have 99% conserved ITS DNA sequences yet differ in their metabolome profiles and virulence over the Brassica cultivars. Out of the ten predicted secretory compounds with their neutral, observed molecular mass and adducts (Table 2), four of them viz. sclerin, sclerone, melanin, and sclerotinin B were reported in earlier studies from S. sclerotiorum [24,47-51]. The remaining six secondary metabolites bostrycoidin, botcinic acid, botcinin A and D, gliovirin, and scleramide were detected for the first instance in S. sclerotiorum culture.
Fungal secondary metabolites have also been shown to bear medicinal and industrial benefits [52]. Bostrycoidin isolated from Fusarium bostrycoides extract was found to bear antibiotic properties [53], whereas bostrycoidin isolated from Fusarium spp. was found phytotoxic and possessed antifungal and bacteriostatic properties [54,55]. Botcinic acid is known to be the phytotoxic compound involved in the virulence of In-silico [20,56]. The BcReg1 knock-out mutants provided proof of concept for botcinic acid and botrydial being the virulence factors in In-silico [22]. Botcinins and botrydial in In-silico are important for virulence as the lack of both toxins leads to reduced disease severity [21,57]. Gliovirin, a diketopiperazine isolated from soil-borne mycoparasite Gliocladium virens showed strong inhibitory activity against Pythium ultimum [58,59]. DHN Melanin is required for making sclerotia a long-lasting persistent resting body synthesized from the compact mycelial mass of the S. sclerotiorum by melanogenesis [24,47]. Melanization protects sclerotia from destruction due to reactive oxygen species (ROS), enzymatic action, and environmental effects like UV exposure [24]. Disruption of genes required for melanogenesis in S. sclerotiorum displayed impaired sclerotia formation and resistance to UV rays [7]. Sclerone, extracted from S. sclerotiorum has also been observed as phytotoxic [51]. Scleramide, a potent antiinsectan, classified as paraherquamide [26] was isolated from the sclerotial extract of Aspergillus sclerotiorum. Sclerin was extracted from S. sclerotiorum which has displayed hormone-like activity in some plants [49]. Sclerin plays a role in regulating enzyme activity in the maturation, and pigmentation of fungal sclerotia, and induces melanogenesis [27,50,60]. Co-metabolites such as sclerotinin A and B, sclerolide, and sclerone were also reported along with sclerin [61]. Sclerotinin A and B are said to be biosynthetic intermediates of sclerin isolated from S. sclerotiorum and showed a growth-promoting effect on rice seedlings [48]. Botcinin A and botcinin D in In-silico extracts showed antifungal activity against Magnaporthe grisea.
The variation in the number and types of secondary metabolites released by different S. sclerotiorum isolates under in vitro culture conditions are largely due to the differences in their growth and developmental stages and their correlation with the virulence over the host can be delineated with the metabolic profiling from the infected tissue samples. The possible reason for the variation in the range of secondary metabolites could be due to the factors involved in the growth culture microenvironment, the developmental stage of the pathogen, and the host-pathogen interaction mechanics. Moreover, the putative secondary metabolites identified in this study are secreted naturally in the growth medium. It has been observed that the profile of the secretory compounds is preferentially governed by the developmental stage of the pathogen; whereas the pathogenicity of the isolates depends on the interacting environments, host architecture, and integral defense mechanisms.
Comparative analysis of the secondary metabolites of S. sclerotiorum isolates from rapeseed mustard has been reported for the first time. The study identified the correlation between the differences in the metabolic profile of S. sclerotiorum isolates with their differential pathogenicity. ESR-04 and ESR-18 had similar metabolites except botcinin A and scleramide but in the cluster dendrogram, both were present in different clades even though they varied in virulence and geographical location. ESR-42 differed from ESR-18 in virulence, but metabolite-based clustering brought ESR-18 and ESR-42 together in a single clade. The analysis showed that many factors come into play at once in deciding pathogen aggression. The type and abundance of the secreted phytotoxic secondary metabolites are an important factor along with the facets of host defense response.
Funding
The research leading to these results received funding from the Department of Biotechnology, Govt. of India under Grant Agreement No. 102/IFD/SAN/3026/2019-20 and institutional support from ICAR-NIPB, New Delhi, India.
Statements and declarations
Pre-print: Gupta NC, Arora S, Kundu A, Sharma P, Rao M, Bhattacharya RC. UPLC-QTOF-MS-Based Untargeted Study of Metabolites Secreted by Sclerotinia sclerotiorum Pathogen Under Axenic Condition. Preprint at:
https://doi.org/10.21203/rs.3.rs-1019583/v1 (2021)
Consent: All authors agreed with the content and approved publishing the manuscript. We obtained the desired consent from the competent authority of the Institute to publish the work and results obtained mentioned in the manuscript.
Data, material and/or code availability
The datasets generated during and/or analyzed during the current study are available from the corresponding author upon reasonable request.
Author’s contribution
Navin C Gupta conceptualized the project and obtained funding from DBT, India; Navin C Gupta and Aditi Kundu performed the experiments; Shaweta Arora and Aditi Kundu analyzed the data; Navin C Gupta, Mahesh Rao, and Shaweta Arora wrote the manuscript; Pankaj Sharma and Ramcharan Bhattacharya further edited the manuscript.
- Bolton MD, Thomma BP, Nelson BD. Sclerotinia sclerotiorum (Lib.) de Bary: biology and molecular traits of a cosmopolitan pathogen. Mol Plant Pathol. 2006; 7(1):1-16.
- Boland GJ, Hall R. Index of plant hosts of Sclerotinia sclerotiorum. Can J Plant Pathol. 1994;16(2):93-108.
- Gupta NC, Sharma P, Rao M, Rai PK, Gupta AK. Evaluation of non-injury inoculation technique for assessing Sclerotinia stem rot (Sclerotinia sclerotiorum) in oilseed Brassica. J Microbiol Methods. 2020 Aug;175:105983. doi: 10.1016/j.mimet.2020.105983. Epub 2020 Jun 13. PMID: 32544486.
- Derbyshire MC, Denton‐Giles M. The control of Sclerotinia stem rot on oilseed rape (Brassica napus): current practices and future opportunities. Plant Pathol. 2016; 65(6):859-77.
- Lv H, Fang Z, Yang L, Zhang Y, Wang Y. An update on the arsenal: mining resistance genes for disease management of Brassica crops in the genomic era. Hortic Res. 2020 Mar 15;7:34. doi: 10.1038/s41438-020-0257-9. PMID: 32194970; PMCID: PMC7072071.
- Ghasolia RP, Shivpuri A, Bhargava AK. Sclerotinia rot of Indian mustard in Rajasthan. Ind Phytopathol. 2004; 57(1):76-9.
- Liang X, Rollins JA. Mechanisms of Broad Host Range Necrotrophic Pathogenesis in Sclerotinia sclerotiorum. Phytopathology. 2018 Oct;108(10):1128-1140. doi: 10.1094/PHYTO-06-18-0197-RVW. Epub 2018 Aug 30. PMID: 30048598.
- Seifbarghi S, Borhan MH, Wei Y, Coutu C, Robinson SJ, Hegedus DD. Changes in the Sclerotinia sclerotiorum transcriptome during infection of Brassica napus. BMC Genomics. 2017 Mar 29;18(1):266. doi: 10.1186/s12864-017-3642-5. PMID: 28356071; PMCID: PMC5372324.
- Bolton MD, Thomma BP, Nelson BD. Sclerotinia sclerotiorum (Lib.) de Bary: biology and molecular traits of a cosmopolitan pathogen. Mol Plant Pathol. 2006 Jan 1;7(1):1-16. doi: 10.1111/j.1364-3703.2005.00316.x. PMID: 20507424.
- Gupta NC, Gupta RK, Rao M, Kumar A. Combining the Sclerotinia stem rot disease resistance trait in interspecific hybrids of Brassica napus and Brassica carinata. Ann Pl Protect Sci. 2019; 27(1):70-6.
- Gupta NC, Yadav S, Arora S, Mishra DC, Budhlakoti N, Gaikwad K, Rao M, Prasad L, Rai PK, Sharma P. Draft genome sequencing and secretome profiling of Sclerotinia sclerotiorum revealed effector repertoire diversity and allied broad-host range necrotrophy. Sci Rep. 2022 Dec 17;12(1):21855. doi: 10.1038/s41598-022-22028-z. PMID: 36528657; PMCID: PMC9759525.
- Pedras MS, Minic Z. Differential protein expression in response to the phytoalexin brassinin allows the identification of molecular targets in the phytopathogenic fungus Alternaria brassicicola. Mol Plant Pathol. 2012 Jun;13(5):483-93. doi: 10.1111/j.1364-3703.2011.00765.x. Epub 2011 Nov 24. PMID: 22111639; PMCID: PMC6638890.
- Zwiers LH, De Waard MA. Characterization of the ABC transporter genes MgAtr1 and MgAtr2 from the wheat pathogen Mycosphaerella graminicola. Fungal Genet Biol. 2000 Jul;30(2):115-25. doi: 10.1006/fgbi.2000.1209. PMID: 11017767.
- Kabbage M, Yarden O, Dickman MB. Pathogenic attributes of Sclerotinia sclerotiorum: switching from a biotrophic to necrotrophic lifestyle. Plant Sci. 2015 Apr;233:53-60. doi: 10.1016/j.plantsci.2014.12.018. Epub 2014 Dec 31. PMID: 25711813.
- AMSElem J, Cuomo CA, van Kan JA, Viaud M, Benito EP, Couloux A, Coutinho PM, de Vries RP, Dyer PS, Fillinger S, Fournier E, Gout L, Hahn M, Kohn L, Lapalu N, Plummer KM, Pradier JM, Quévillon E, Sharon A, Simon A, ten Have A, Tudzynski B, Tudzynski P, Wincker P, Andrew M, Anthouard V, Beever RE, Beffa R, Benoit I, Bouzid O, Brault B, Chen Z, Choquer M, Collémare J, Cotton P, Danchin EG, Da Silva C, Gautier A, Giraud C, Giraud T, Gonzalez C, Grossetete S, Güldener U, Henrissat B, Howlett BJ, Kodira C, Kretschmer M, Lappartient A, Leroch M, Levis C, Mauceli E, Neuvéglise C, Oeser B, Pearson M, Poulain J, Poussereau N, Quesneville H, Rascle C, Schumacher J, Ségurens B, Sexton A, Silva E, Sirven C, Soanes DM, Talbot NJ, Templeton M, Yandava C, Yarden O, Zeng Q, Rollins JA, Lebrun MH, Dickman M. Genomic analysis of the necrotrophic fungal pathogens Sclerotinia sclerotiorum and Botrytis cinerea. PLoS Genet. 2011 Aug;7(8):e1002230. doi: 10.1371/journal.pgen.1002230. Epub 2011 Aug 18. PMID: 21876677; PMCID: PMC3158057.
- Li R, Rimmer R, Buchwaldt L, Sharpe AG, Séguin-Swartz G, Hegedus DD. Interaction of Sclerotinia sclerotiorum with Brassica napus: cloning and characterization of endo- and exo-polygalacturonases expressed during saprophytic and parasitic modes. Fungal Genet Biol. 2004 Aug;41(8):754-65. doi: 10.1016/j.fgb.2004.03.002. PMID: 15219560.
- Riou C, Freyssinet G, Fevre M. Purification and Characterization of Extracellular Pectinolytic Enzymes Produced by Sclerotinia sclerotiorum. Appl Environ Microbiol. 1992 Feb;58(2):578-83. doi: 10.1128/aem.58.2.578-583.1992. PMID: 16348646; PMCID: PMC195287.
- Allan J, Regmi R, Denton-Giles M, Kamphuis LG, Derbyshire MC. The host generalist phytopathogenic fungus Sclerotinia sclerotiorum differentially expresses multiple metabolic enzymes on two different plant hosts. Sci Rep. 2019 Dec 27;9(1):19966. doi: 10.1038/s41598-019-56396-w. PMID: 31882688; PMCID: PMC6934579.
- Blanco-Ulate B, Morales-Cruz A, Amrine KC, Labavitch JM, Powell AL, Cantu D. Genome-wide transcriptional profiling of Botrytis cinerea genes targeting plant cell walls during infections of different hosts. Front Plant Sci. 2014 Sep 3;5:435. doi: 10.3389/fpls.2014.00435. PMID: 25232357; PMCID: PMC4153048.
- Colmenares AJ, Aleu J, Durán-Patrón R, Collado IG, Hernández-Galán R. The putative role of botrydial and related metabolites in the infection mechanism of Botrytis cinerea. J Chem Ecol. 2002 May;28(5):997-1005. doi: 10.1023/a:1015209817830. PMID: 12049236.
- Dalmais B, Schumacher J, Moraga J, LE Pêcheur P, Tudzynski B, Collado IG, Viaud M. The Botrytis cinerea phytotoxin botcinic acid requires two polyketide synthases for production and has a redundant role in virulence with botrydial. Mol Plant Pathol. 2011 Aug;12(6):564-79. doi: 10.1111/j.1364-3703.2010.00692.x. Epub 2011 Jan 17. PMID: 21722295; PMCID: PMC6640383.
- Michielse CB, Becker M, Heller J, Moraga J, Collado IG, Tudzynski P. The Botrytis cinerea Reg1 protein, a putative transcriptional regulator, is required for pathogenicity, conidiogenesis, and the production of secondary metabolites. Mol Plant-Microbe Interact. 2011;24(9):1074-85.
- Taylor A, Coventry E, Handy C, West JS, Young CS, Clarkson JP. Inoculum potential of Sclerotinia sclerotiorum sclerotia depends on isolate and host plant. Plant Pathol. 2018;67:1286-95.
- Butler MJ, Gardiner RB, Day AW. Melanin synthesis by Sclerotinia sclerotiorum. Mycologia. 2009 May-Jun;101(3):296-304. doi: 10.3852/08-120. PMID: 19537203.
- Xia S, Xu Y, Hoy R, Zhang J, Qin L, Li X. The Notorious Soilborne Pathogenic Fungus Sclerotinia sclerotiorum: An Update on Genes Studied with Mutant Analysis. Pathogens. 2019 Dec 27;9(1):27. doi: 10.3390/pathogens9010027. PMID: 31892134; PMCID: PMC7168625.
- Whyte AC, Joshi BK, Gloer JB, Wicklow DT, Dowd PF. New cyclic peptide and bisindolyl benzenoid metabolites from the sclerotia of Aspergillus sclerotiorum. J Nat Prod. 2000 Jul;63(7):1006-9. doi: 10.1021/np000103v. PMID: 10924188.
- Barber J, Garson MJ, Staunton J. The biosynthesis of fungal metabolites: sclerin, a plant growth hormone from Sclerotinia sclerotiorum. J Chem Soc, Perkin Trans. 1981; 1:2584-93.
- Liang X, Liberti D, Li M, Kim YT, Hutchens A, Wilson R, Rollins JA. Oxaloacetate acetylhydrolase gene mutants of Sclerotinia sclerotiorum do not accumulate oxalic acid, but do produce limited lesions on host plants. Mol Plant Pathol. 2015 Aug;16(6):559-71. doi: 10.1111/mpp.12211. Epub 2014 Dec 15. PMID: 25285668; PMCID: PMC6638444.
- Pedras MS, Ahiahonu PW. Phytotoxin production and phytoalexin elicitation by the phytopathogenic fungus Sclerotinia sclerotiorum. J Chem Ecol. 2004 Nov;30(11):2163-79. doi: 10.1023/b:joec.0000048781.72203.6c. PMID: 15672663.
- Sharma P, Samkumar A, Rao M, Singh VV, Prasad L, Mishra DC, Bhattacharya R, Gupta NC. Genetic Diversity Studies Based on Morphological Variability, Pathogenicity and Molecular Phylogeny of the Sclerotinia sclerotiorum Population From Indian Mustard (Brassica juncea). Front Microbiol. 2018 Jun 5;9:1169. doi: 10.3389/fmicb.2018.01169. PMID: 29922259; PMCID: PMC5996862.
- Kundu A, Saha S, Walia S, Dutta TK. Anti-nemic secondary metabolites produced by Fusarium oxysporum f. sp. ciceris. J Asia-Pacific Entomol. 2016; 19(3):631-36.
- Amaradasa BS, Everhart SE. Effects of Sublethal Fungicides on Mutation Rates and Genomic Variation in Fungal Plant Pathogen, Sclerotinia sclerotiorum. PLoS One. 2016 Dec 13;11(12):e0168079. doi: 10.1371/journal.pone.0168079. PMID: 27959950; PMCID: PMC5154572.
- Le Cointe R, Simon TE, Delarue P, Hervé M, Leclerc M, Poggi S. Reducing the Use of Pesticides with Site-Specific Application: The Chemical Control of Rhizoctonia solani as a Case of Study for the Management of Soil-Borne Diseases. PLoS One. 2016 Sep 26;11(9):e0163221. doi: 10.1371/journal.pone.0163221. PMID: 27668731; PMCID: PMC5036793.
- Neik TX, Barbetti MJ, Batley J. Current Status and Challenges in Identifying Disease Resistance Genes in Brassica napus. Front Plant Sci. 2017 Nov 6;8:1788. doi: 10.3389/fpls.2017.01788. PMID: 29163558; PMCID: PMC5681527.
- Atallah ZK, Larget B, Chen X, Johnson DA. High genetic diversity, phenotypic uniformity, and evidence of outcrossing in Sclerotinia sclerotiorum in the columbia basin of washington state. Phytopathology. 2004 Jul;94(7):737-42. doi: 10.1094/PHYTO.2004.94.7.737. PMID: 18943906.
- Uloth MB, Clode PL, You MP, Barbetti MJ. Attack modes and defence reactions in pathosystems involving Sclerotinia sclerotiorum, Brassica carinata, B. juncea and B. napus. Ann Bot. 2016 Jan;117(1):79-95. doi: 10.1093/aob/mcv150. Epub 2015 Sep 29. PMID: 26420204; PMCID: PMC4701150.
- Uloth MB, You MP, Finnegan PM, Banga SS, Banga SK, Sandhu PS. et al. New sources of resistance to Sclerotinia sclerotiorum for crucifer crops. Field Crops Res. 2013; 154:40-52.
- Miorini TJ, Kamvar ZN, Higgins RS, Raetano CG, Steadman JR, Everhart SE. Differential aggressiveness of Sclerotinia sclerotiorum isolates from North and South America and partial host resistance in Brazilian soybean and dry bean cultivars. Trop Plant Pathol. 2019; 44(1):73-81.
- Graham-Taylor C, Kamphuis LG, Derbyshire MC. A detailed in silico analysis of secondary metabolite biosynthesis clusters in the genome of the broad host range plant pathogenic fungus Sclerotinia sclerotiorum. BMC Genomics. 2020 Jan 2;21(1):7. doi: 10.1186/s12864-019-6424-4. PMID: 31898475; PMCID: PMC6941272.
- Bignell E, Cairns TC, Throckmorton K, Nierman WC, Keller NP. Secondary metabolite arsenal of an opportunistic pathogenic fungus. Philos Trans R Soc Lond B Biol Sci. 2016 Dec 5;371(1709):20160023. doi: 10.1098/rstb.2016.0023. PMID: 28080993; PMCID: PMC5095546.
- Raffa N, Keller NP. A call to arms: Mustering secondary metabolites for success and survival of an opportunistic pathogen. PLoS Pathog. 2019 Apr 4;15(4):e1007606. doi: 10.1371/journal.ppat.1007606. PMID: 30947302; PMCID: PMC6448812.
- Macheleidt J, Mattern DJ, Fischer J, Netzker T, Weber J, Schroeckh V, Valiante V, Brakhage AA. Regulation and Role of Fungal Secondary Metabolites. Annu Rev Genet. 2016 Nov 23;50:371-392. doi: 10.1146/annurev-genet-120215-035203. Epub 2016 Oct 5. PMID: 27732794.
- Collemare J, Seidl MF. Chromatin-dependent regulation of secondary metabolite biosynthesis in fungi: is the picture complete? FEMS Microbiol Rev. 2019 Nov 1;43(6):591-607. doi: 10.1093/femsre/fuz018. PMID: 31301226; PMCID: PMC8038932.
- Brakhage AA. Regulation of fungal secondary metabolism. Nat Rev Microbiol. 2013 Jan;11(1):21-32. doi: 10.1038/nrmicro2916. Epub 2012 Nov 26. PMID: 23178386.
- Díaz R, Ibáñez M, Sancho JV, Hernández F. Target and non-target screening strategies for organic contaminants, residues, and illicit substances in food, environmental and human biological samples by UHPLC-QTOF-MS. Anal Methods. 2012; 4(1):196-209.
- Chen S, Li M, Zheng G, Wang T, Lin J, Wang S, Wang X, Chao Q, Cao S, Yang Z, Yu X. Metabolite Profiling of 14 Wuyi Rock Tea Cultivars Using UPLC-QTOF MS and UPLC-QqQ MS Combined with Chemometrics. Molecules. 2018 Jan 24;23(2):104. doi: 10.3390/molecules23020104. PMID: 29364152; PMCID: PMC6017971.
- Butler MJ, Gardiner RB, Day AW. Degradation of melanin or inhibition of its synthesis: are these a significant approach as a biological control of phytopathogenic fungi? Biological Control. 2005; 32(2):326-36.
- Sassa T, Aoki H, Namiki M, Munakata K. Plant Growth Promoting metabolites of Sclerotinia sclerotiorum: Part I. Isolation and Structures of Sclerotinin A and B. Agricultural and Biological Chemistry. 1998; 32(12):1432-1439.
- Satomura Y, Sato A. Isolation and physiological activity of sclerin, a metabolite of Sclerotinia fungus. Agricultural and Biological Chemistry. 1965; 29(4):337-44.
- Marukawa S, Funakawa S, Satomura Y. Role of sclerin on morphogenesis in Sclerotinia sclerotiorum de Bary (including S. libertiana Fuckel). Agricultural and Biological Chemistry. 1975; 39(3):645-50.
- Suzuki K, Sassa T, Tanaka H, Aoki H, Namiki M. Sclerone, a new metabolite of Sclerotinia sclerotiorum (Lib) DE BARY. Agricultural and Biological Chemistry. 1968; 32(12):1471-75.
- Pusztahelyi T, Holb IJ, Pócsi I. Secondary metabolites in fungus-plant interactions. Front Plant Sci. 2015 Aug 6;6:573. doi: 10.3389/fpls.2015.00573. PMID: 26300892; PMCID: PMC4527079.
- Dame ZT, Silima B, Gryzenhout M, van Ree T. Bioactive compounds from the endophytic fungus Fusarium proliferatum. Nat Prod Res. 2016 Jun;30(11):1301-4. doi: 10.1080/14786419.2015.1053089. Epub 2015 Jul 9. PMID: 26158312.
- Arsenault GP. The structure of bostrycoidin, a β-aza-anthraquinone from Fusarium solani D2 purple. Tetrahedron Letters. 1965; 6(45):4033-37.
- Giannini G, Penco S, Pisano C, Riccioni T, Nasini G, Candiani G. Chrysanthones, a new source of fungal metabolites with potential antitumor and antiangiogenesis properties. Fitoterapia. 2003 Jun;74(4):323-7. doi: 10.1016/s0367-326x(03)00059-5. PMID: 12781801.
- Porquier A, Moraga J, Morgant G, Dalmais B, Simon A, Sghyer H, Collado IG, Viaud M. Botcinic acid biosynthesis in Botrytis cinerea relies on a subtelomeric gene cluster surrounded by relics of transposons and is regulated by the Zn2Cys6 transcription factor BcBoa13. Curr Genet. 2019 Aug;65(4):965-980. doi: 10.1007/s00294-019-00952-4. Epub 2019 Mar 8. PMID: 30848345.
- Schumacher J, Tudzynski P. Morphogenesis and Pathogenicity in Fungi. TCG. 2012; 22:243-64.
- Howell CR, Stipanovic RD. Gliovirin, a new antibiotic from Gliocladium virens, and its role in the biological control of Pythium ultimum. Canad J Microbiol. 1983; 29(3):321-24.
- Howell CR, Stipanovic RD, Lumsden RD. Antibiotic production by strains of Gliocladium virens and its relation to the biocontrol of cotton seedling diseases. Biocontrol Sci Technol. 1993; 3(4):435-441.
- Tellenbach C, Sumarah MW, Grünig CR, Miller JD. Inhibition of Phytophthora species by secondary metabolites produced by the dark septate endophyte Phialocephala europaea. Fungal Ecol. 2013; 6(1):12-18.
- Tokoroyama T, Kubota T. The structure and synthesis of sclerolide. Tetrahedron. 1970 Feb;26(4):1085-90. doi: 10.1016/s0040-4020(01)98784-8. PMID: 5443309.